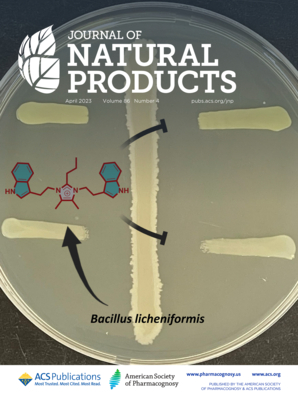

Discovery of new functional materials and phytochemical synthesis based on expertise in individually approved ingredient development.

Discovery of new materials through elucidation of effective chemical mechanisms of gut microbial metabolites.

Patent No. 10-1516012
Development of medical waste treatment system
Patent No. 10-1516012
Development of medical waste treatment system
 Patent No. 10-2406855
Cancer diagnosis immunosensor using signal-labeling probes and cancer diagnostic chip employing it
Patent No. 10-2406855
Cancer diagnosis immunosensor using signal-labeling probes and cancer diagnostic chip employing it
 Patent No. 10-2025271
Fluorescent particles containing polystyrene beads and carbon quantum dots, and their applications
Patent No. 10-2025271
Fluorescent particles containing polystyrene beads and carbon quantum dots, and their applications
EcoPrime Co., Ltd.